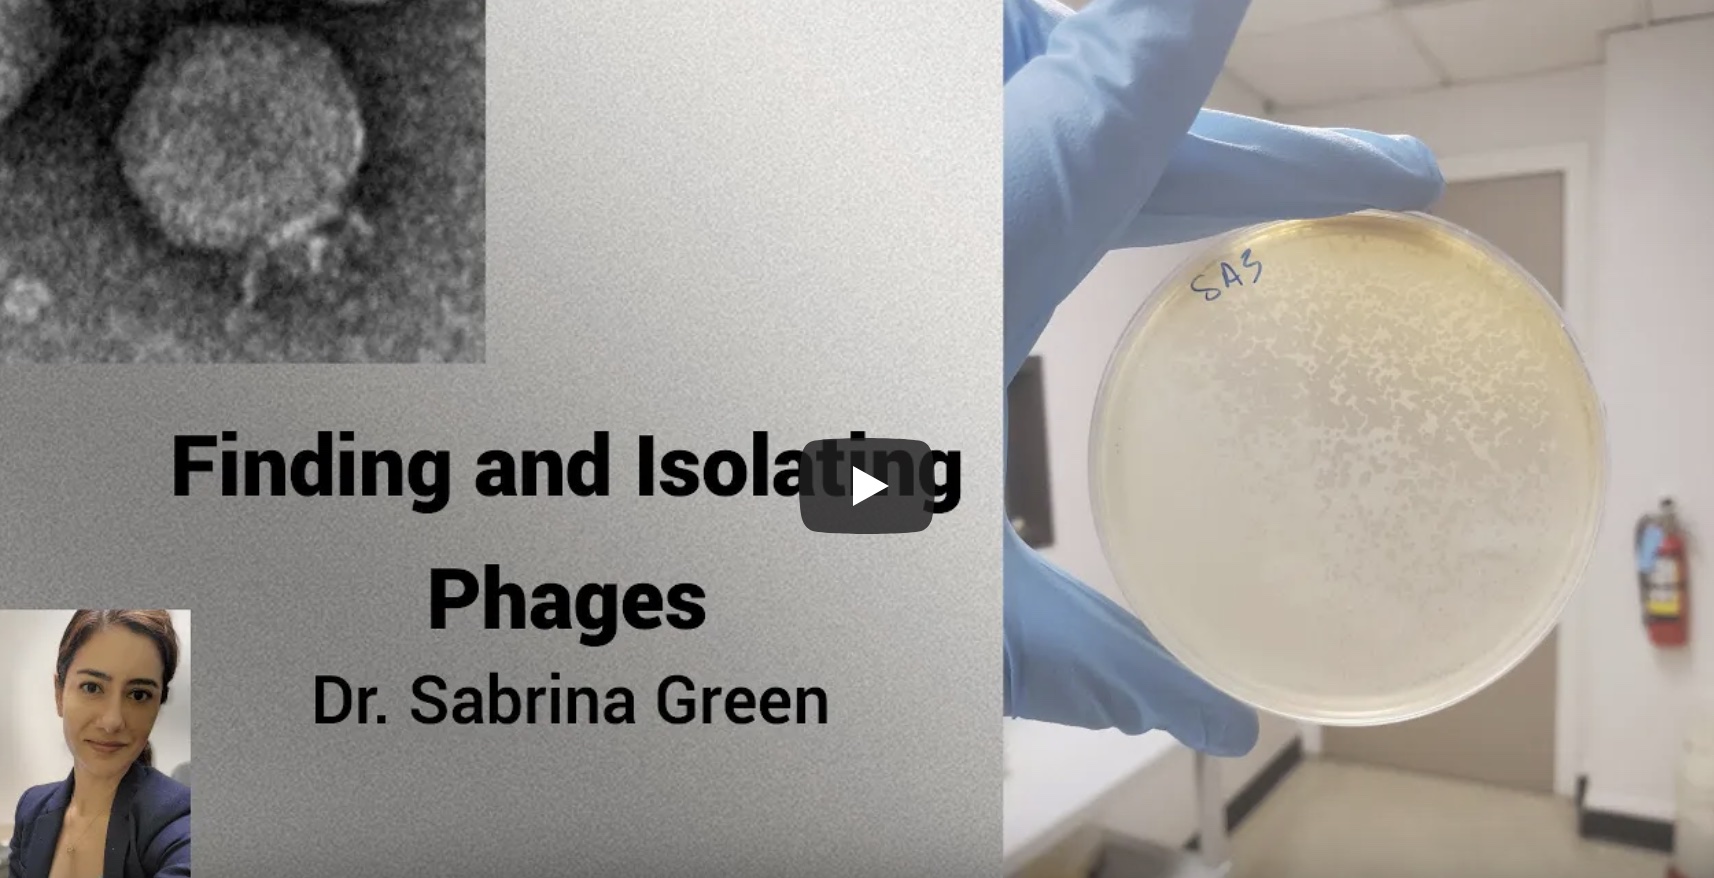

Howdy, I’m Sabrina.
[Mother of Phage]
I am a phage therapy researcher and general phage enthusiast.
Some people keep asking me “how do I get phage therapy?” It’s a difficult question to answer because it will vary depending on the country you live in. Also, it will vary depending on your situation. I provided you with some links below.
- UK
- Israel
- US
- US Seaphages
- US TAILOR
- Canada
- Australia
- Australia Melbourne
- Georgia
- Poland
- Germany
- Belgium
- Portugal
- The Queen Astrid Military Hospital in Belgium also offers an email contact for inquiries about phage therapy. However, phages are only provided to licensed medical doctors, not directly to patients. Therefore, it is essential to have the support of your treating physician to pursue this therapy. Additionally, due to certain limitations, priority is given to patients with difficult-to-treat infections. Email pt@mil.be
I like to do scicomm. Here are some videos links below.
- Dr. Sabrina Green on TAILORing phage therapy for the gut and beyond. This is a video from Phage Directory Phaves seminar where I discuss how gut phages are very specific to their environment. Click here.

- What is Bacteriophage therapy? Dr. Sabrina Green, Dr. Saima Aslam and Dr. Austen Terwilliger, Part 1, Part 2 and 3. Here we discuss about what TAILOR is doing in phage therapy and UTI’s. How phages can help chronic UTI sufferers. Here are the links to Part I, Part II and Part III.

- This is an ASM Microtalks where I speak about our gut phages work. For link click here.

- I did some how-to videos the 1st was Finding and Isolating Phages. I teach about the basics. Click here.
- Here is me showing how to purify a phage. Click here.

- Here is where I introduce the phage center we started in Houston, Texas called TAILOR. Click here.

- This where I explain our expedited pipeline to phage therapy. Click here.

- This is the most current video of our work going on to help Ukraine by providing them with phages. In Dutch TV. Click here.

Here are some podcasts too!
- Phage Therapy Today Podcast “Exploration and Phage Therapy” @BCM TailorLabs with Dr. Sabrina Green. Click here.
- The Bioinformatics and Beyond Podcast Dr. Sabrina Green: Phages and Phage Discovery. Click here.
- The Bionformatics and Beyond Podcast. Part II Dr. Sabrina Green: Clinical Use of Phages. Click here.
- I wrote and directed this episode of the podcast Resonance. I interview Dr. Anthony Maresso and Dr. Barbara Trautner. Click here.
- This is an ASM Microcast. Using Viruses to Cure Bacterial Infections — All about Phage Therapy with Dr. Sabrina Green. Click here.
- Here I was on the Canadian radio show called Quirks and Quarks Bacteria-hunting viruses can track down antibiotic-resistant bugs where they hide. This was interesting because at the time I was in a closet with no electricity due to the recent winter storm in Houston. Click here.
I wrote and contributed to some blogs and newsletters!
- This is a Phage Directory blog I wrote about Gut Phages. Click here.
- This is another Phage Directory blog I co-wrote Tailoring phages for patients: Inside Baylor College of Medicine’s TAILΦR initiative. Click here.
- I wrote this for the CURE asthma and EU project to use phages for asthma. Click here.
- I was interviewed for this blog called Promega Connections Phage Therapy: Meeting the Challenge of Drug-Resistant infections. Click here.
- This is in Spanish from El Mundo. I was interviewed for called Virus: un inesperado aliado frente a las ‘superbacterias’. Click here.
- This is from the Blog Happiest Health I was interviewed for Bacteriophage therapy: an age-old answer to combat antibiotic resistance. Click here.
- This is something I wrote for Springer Nature blogs called Phage therapy is back, it’s promising and it’s going to take structural support to keep it going. This is about our recent Nature Microbiology paper detailing 100 cases of phage therapy facilitated by our Belgian consortium. Click here.
- This is a recent MIT science policy review I was interviewed for. Click here.
I recently wrote something for Nature Microbiology about Scicomm for phage therapy. Click here.
Did you know we had a podcast called Phage Phriday? Well we are working on converting these episodes to Spotify. Stay tuned…
CONTACT ME IF YOU WANT BUT PLEASE HAVE SOME PURPOSE.